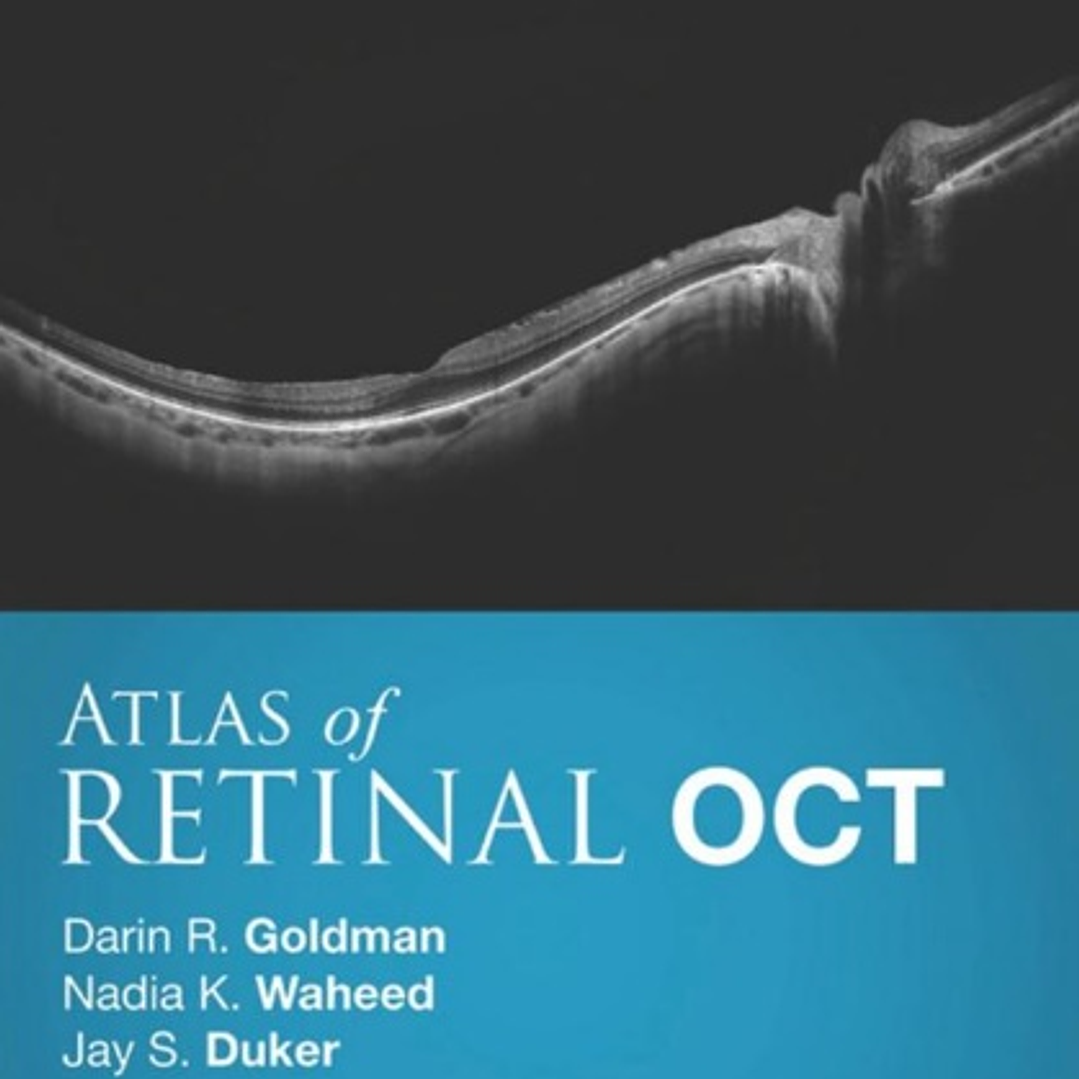

|
Atlas of Retinal OCT: Optical Coherence Tomography
Description
1st Edition
by Darin Goldman (Author), Nadia K Waheed (Author), Jay S. Duker (Author)
Optical Coherence Tomography has revolutionized today’s eye care. This remarkable non-invasive scanning technology is unparalleled for aiding diagnosis of retinal disease and recording disease progression. Atlas of Retinal OCT: Optical Coherence Tomography provides expert guidance in this rapidly evolving area with high-quality, oversized images that show precise detail and assist with rapid, accurate clinical decision making.
- Features more than 1,000 superb illustrations depicting the full spectrum of retinal diseases using OCT scans, supported by clinical photos and ancillary imaging technologies.
- Presents images as large as possible on the page with an abundance of arrows, pointers, and labels to guide you in pattern recognition and eliminate any uncertainty.
- Includes the latest high-resolution spectral domain OCT technology and new insights into OCT angiography technology to ensure you have the most up-to-date and highest quality examples available.
- Provides key feature points for each disorder giving you the need-to-know OCT essentials for quick comprehension and rapid reference.
- An excellent diagnostic companion to Handbook of Retinal OCT: Optical Coherence Tomography, by the same expert author team of Drs. Jay S. Duker, Nadia K. Waheed, and Darin R. Goldman.
- Expert Consult™ eBook version included with purchase. This enhanced eBook experience allows you to search all of the text, figures, Q&As, and references from the book on a variety of devices.
Details
Year:
2019
Pages:
200
Language:
English
Format:
PDF
Size:
123 MB
ISBN-10:
9.78032E+12
ISBN-13:
978-0323461214
ASIN:
0323461212, B07796YV3Q